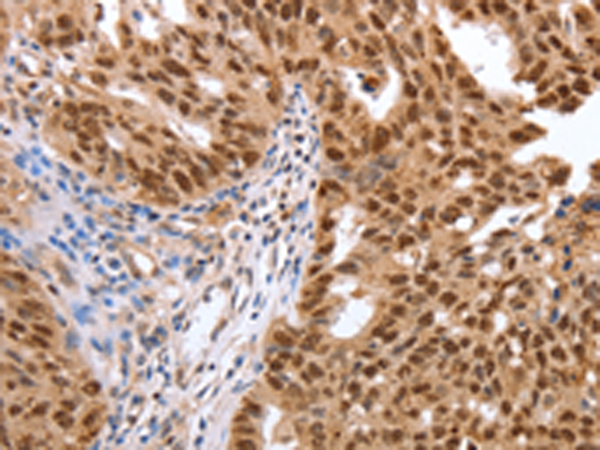
一抗

中文名稱: 兔抗PARP1多克隆抗體
英文名稱: Anti-PARP1 rabbit polyclonal antibody
別 名: PARP, PPOL, ADPRT, ARTD1, ADPRT1, PARP-1, ADPRT 1, pADPRT-1
相關類別: 一抗
儲 存: 冷凍(-20℃)
宿 主: Rabbit
抗 原: PARP1
反應種屬: Human, Mouse, Rat
標 記 物: Unconjugate
克隆類型: rabbit polyclonal
技術規格
|
Background: |
This gene encodes a chromatin-associated enzyme, poly(ADP-ribosyl)transferase, which modifies various nuclear proteins by poly(ADP-ribosyl)ation. The modification is dependent on DNA and is involved in the regulation of various important cellular processes such as differentiation, proliferation, and tumor transformation and also in the regulation of the molecular events involved in the recovery of cell from DNA damage. In addition, this enzyme may be the site of mutation in Fanconi anemia, and may participate in the pathophysiology of type I diabetes. |
|
Applications: |
ELISA, WB, IHC |
|
Name of antibody: |
PARP1 |
|
Immunogen: |
Synthetic peptide of human PARP1 |
|
Full name: |
poly (ADP-ribose) polymerase 1 |
|
Synonyms: |
PARP, PPOL, ADPRT, ARTD1, ADPRT1, PARP-1, ADPRT 1, pADPRT-1 |
|
SwissProt: |
P09874 |
|
ELISA Recommended dilution: |
2000-5000 |
|
IHC positive control: |
Human liver cancer and Human breast cancer |
|
IHC Recommend dilution: |
25-100 |
|
WB Predicted band size: |
113 kDa |
|
WB Positive control: |
Jurkat and Hela cells |
|
WB Recommended dilution: |
500-2000 |


 購物車
購物車 幫助
幫助
 021-54845833/15800441009
021-54845833/15800441009